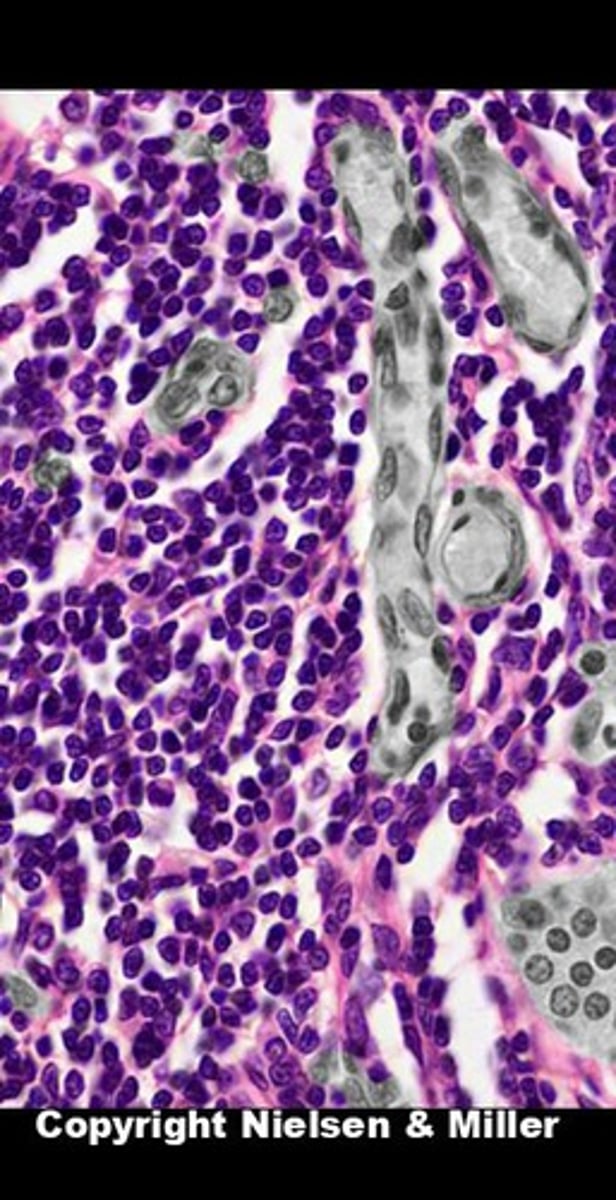
knowt flashcard image

1/214
Looks like no tags are added yet.
Name | Mastery | Learn | Test | Matching | Spaced | Call with Kai |
|---|
No analytics yet
Send a link to your students to track their progress
Adrenal cortex - histology

Adrenal medulla - histology

Adrenal gland

Adventitia

Alveoli

Anal sphincters

Antrum of stomach

Anus

Aorta

Aorta

Aortic valve

Aortic valve

Atrioventricular groove

Basophils
least common granulocyte
histamine and heparin released for inflammatory or allergic reaction

Bicuspid valve

Bicuspid valve

Bipolar nerve of olfactory epithelium

Body of stomach

Brachial plexus

Brachial plexus

Canine

Cecum

Chief cells (parathyroid gland)
Choroid plexus

Cilia

Cochlea

Cochlea cross section

Cochlea

Colloid of thyroid

Colon

Cords of brachial plexus

Cornea

Coronary sinus

Coronary sinus

CN I - Olfactory

CN II - Optic

CN III - Oculomotor

CN IV - Trochlear

CN V - Trigeminal

CN VI - Abducens

CN VII - Facial

CN VIII - Vestibulocochlear

CN IX - Glossopharyngeal

CN X - Vagus

CN XI - Accessory

CN XII - Hypoglossal

Cricoid cartilage

Cricoid cartilage

Diaphragm muscle

Diaphragm muscle

Diaphragm muscle

Dorsal root of spinal nerve

Duodenum

Duodenum

Ear anatomy

Ear anatomy

Ear anatomy

Ear anatomy

Eosinophils
defend body vs allergies or parasitic infection

Epiglottis

Epiglottis

Esophagus

Esophagus

Esophagus

Ethmoid bone

Ethmoid sinuses

External anal sphincter

Eye anatomy

Eye anatomy

Eye anatomy

Eye anatomy

Follicular cell - thyroid

Fossa ovalis

Frontal sinus

Frontal sinus

Fundus of stomach

Goblet cell

Great cardiac vein

Greater curvature

Greater omentum

Heart valves

Heart

Hilum of lung

Histology - Pancreas

Histology - Duodenum (brunner gland)

Histology - Thyroid gland

Histology - Nervous tissue

Ileum

Incisor teeth

Incus

Inferior lobe of lung

Inferior nasal concha

Inferior oblique

Inferior rectus

Inferior trunk of brachial plexus

Inferior vena cava

Interatrial septum

Interventricular septum

Interventricular sulcus

Jejunum
